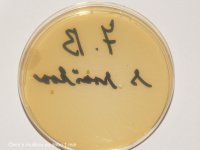
7.B čtení s rouškou.jpg
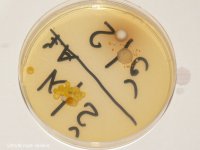
7.jpg
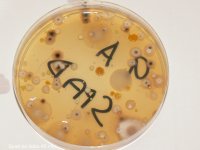
9.A spad-1.jpg

Mikroorganismy kolem nás
Mikroorganismy kolem nás
Skutečnost, že je velké množství mikroorganismů kolem nás i v nás, je pravdivá. Příliš si to ale nepřipouštíme, nevidíme je. Již na začátku září jsem proto, s pomocí PřF UK, naplánovala "pokus", ve kterém by se děti přesvědčily o tom, že bakterie a plísně jsou opravdu všude. Původně jsem naplánovala zjistit přítomnost mikroorganismů na umytých a neumytých rukou a přítomnost mikroorganismů v ovzduší ve třídě. Vzhledem k situaci k tomu přibyla ještě varianta mluvení nad Petriho miskou s rouškou a bez roušky.
Pokus probíhal ve třídách 7.A, 7.B, 8.A, 8.B a 9.A. Ostatní třídy to bohužel nestihly, uzavřela se škola. Růst bakterií a plísní pak neprobíhal v ideálních podmínkách. Rostly zhruba týden při pokojové teplotě a poblíž okna.
Přítomnost mikroorganismů ve třídách jsme zjišťovali tak, že sterilní miska s živnou půdou byla ponechána otevřená ve třídě po dobu zhruba 45 minut. Na fotodokumentaci je vidět, že nám jich na živné půdě vyrostlo docela dost. A poučení: nenechávat zejména uvařené pokrmy dlouho bez zakrytí a bez chladničky.
Zjišťovali jsme i přítomnost mikroorganismů na umytých rukou a rukou neumytých. Děti si ale myly ruce kratší dobu než 30s a pouze pod studenou vodou. Na Petriho miskách je tak vidět, že i takto umyté ruce jsou kontaminovány. Poučení: mýt si ruce delší dobu a s použitím teplé vody.
Čtení s rouškou, případně bez roušky, probíhalo tak, že děti četly 1 minutu text nad otevřenou Petriho miskou.
Fotodokumentaci si děti mohou podrobně prohlédnout ve škole. Zde přidávám pouze pár fotografií. J. Horníčková